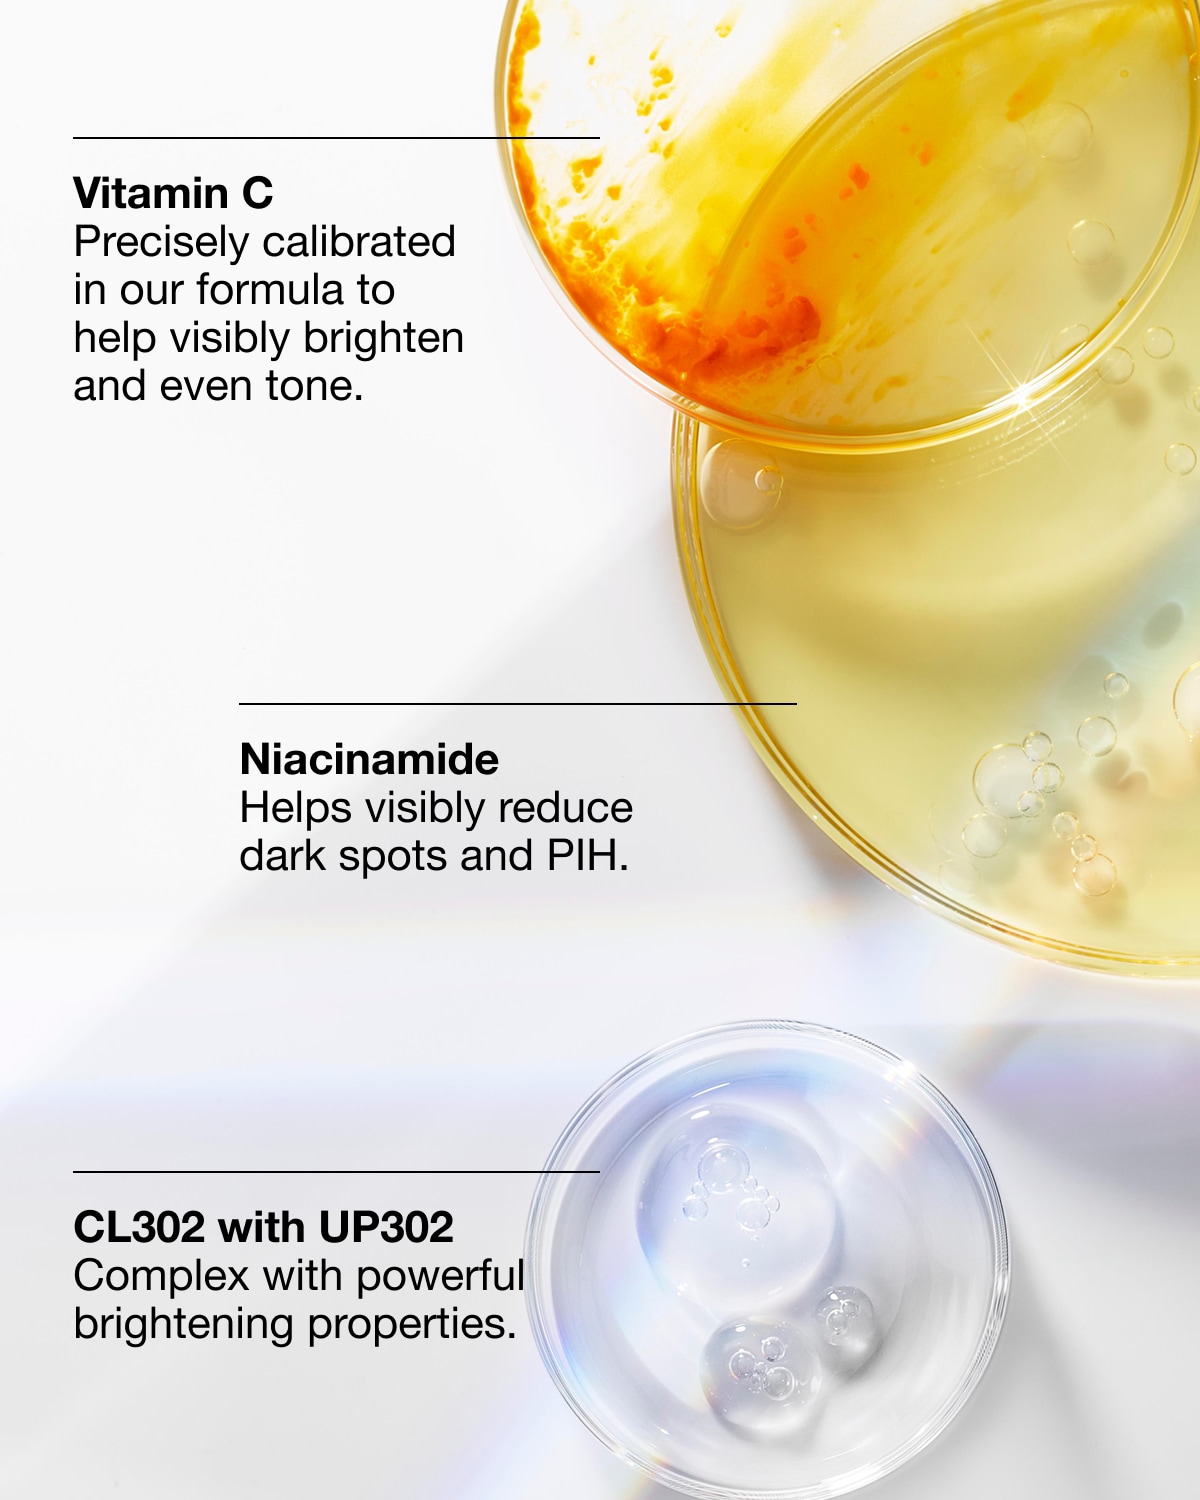

Even Better Clinical™ Dark Spot Clearing Serum
סרום עוצמתי להבהרת כתמי עור כהים וטיפול בגוון עור לא אחיד.
מרכיבים עיקריים
UP302, ויטמין C , ניאצינאמיד, חומצה סליצילית, גלוקוזאמין
50 מ"ל

UP302, ויטמין C , ניאצינאמיד, חומצה סליצילית, גלוקוזאמין